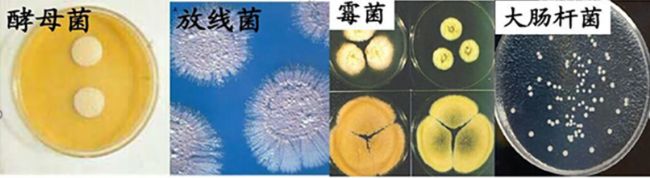
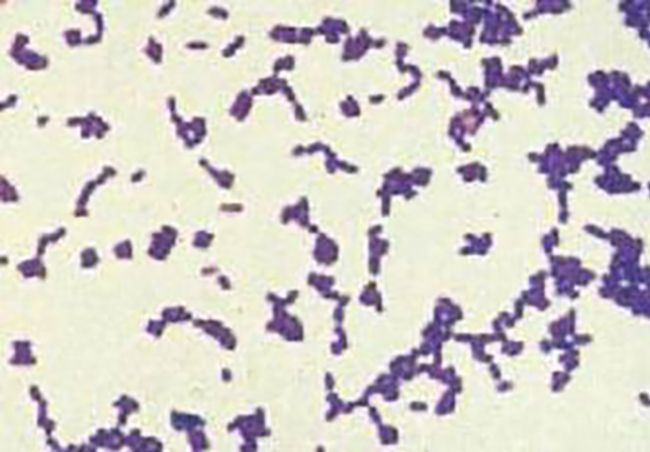
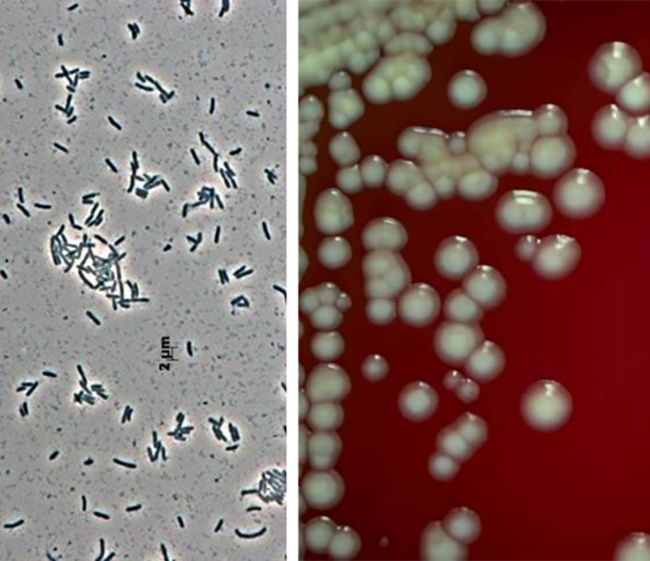
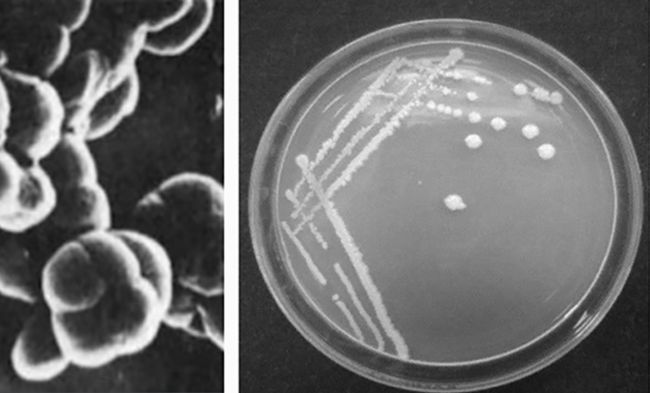
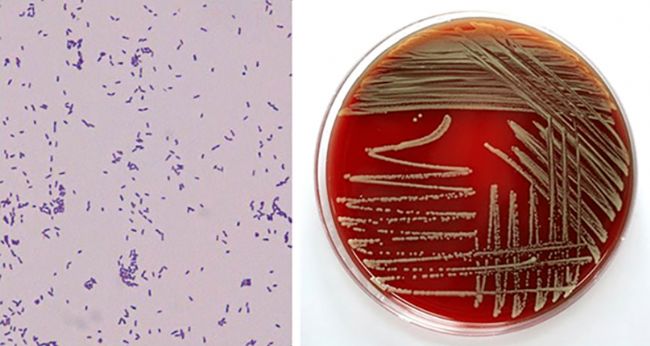

上期我們與大家一起分析鑒定了支原體樣本,
今天繼續(xù)來(lái)看看剩下的細(xì)菌樣本。
江湖上流傳很久的黑膠蟲(chóng),到底真實(shí)身份是啥?
我們一起來(lái)扒一扒~
逍鵬生物收集了全國(guó)29個(gè)黑膠蟲(chóng)污染樣本進(jìn)行DNA提取、測(cè)序、數(shù)據(jù)庫(kù)比對(duì),得到鑒定結(jié)果。
在這29個(gè)樣本中,有11個(gè)樣本鑒定為支原體,種類分別為豬鼻支原體、牛支原體、鼠肺支原體、山羊支原體。18個(gè)樣本鑒定為細(xì)菌,種類分別為放線菌屬、羅爾斯通菌屬、短波單胞菌屬、泳池芽殖單胞菌、假單胞菌、鞘氨醇單胞菌、甲基菌屬、微桿菌屬、赫氏草螺菌。

接下來(lái)我們分析一下剩余的18個(gè)被鑒定為細(xì)菌的黑膠蟲(chóng)樣本
首先我們來(lái)了解一下細(xì)菌基本特征
# 細(xì)菌污染 #

定義:一類細(xì)胞細(xì)短,結(jié)構(gòu)簡(jiǎn)單,胞壁堅(jiān)韌,多以二分裂方式繁殖和水生性強(qiáng)的原核生物。
結(jié)構(gòu):主要是單細(xì)胞的原核生物,有球形,桿形,螺旋形,放線形;窘Y(jié)構(gòu):細(xì)胞膜、細(xì)胞壁、細(xì)胞質(zhì)、擬核。特殊結(jié)構(gòu):莢膜、鞭毛、菌毛、芽胞。大家注意,鞭毛多一些游動(dòng)相對(duì)活躍,鞭毛少一些可能會(huì)原地大鉆,顫動(dòng),這就和我們觀察到的黑膠蟲(chóng)現(xiàn)象相吻合了。
繁殖:多數(shù)細(xì)菌主要以二分裂方式進(jìn)行繁殖。
圖7. 菌落圖
圖源網(wǎng)絡(luò),僅供參考學(xué)習(xí)用
這里有一些菌落的形態(tài)供大家欣賞一下,不同的微生物形成的菌落在形態(tài)、突起、邊緣上具有不同的特征,是鑒別菌種的重要依據(jù)。
酵母菌和霉菌屬于真菌,有成型的細(xì)胞核,放線菌和大腸桿菌屬于細(xì)菌,兩者有本質(zhì)的區(qū)別,前者有核膜包圍的細(xì)胞核,后者沒(méi)有。酵母菌的菌落呈白色光滑原斑;霉菌的菌落相對(duì)其它菌都比較大,會(huì)呈現(xiàn)青綠、灰黑等顏色;放線菌菌落呈明顯的放射狀,菌落也相對(duì)較大;大腸桿菌的菌落呈白色小圓點(diǎn),和酵母菌菌落有相似之處。

圖8. 細(xì)菌形態(tài)(來(lái)源:百度百科)
細(xì)菌主要有兩種劃分標(biāo)準(zhǔn)。
根據(jù)形狀主要分為三類:球菌、桿菌、螺旋菌(包括弧菌、螺菌、螺桿菌);
圖9. 革蘭氏陽(yáng)性菌
圖源網(wǎng)絡(luò),僅供參考學(xué)習(xí)用
根據(jù)細(xì)胞壁的組成成分又分為革蘭氏陽(yáng)性菌和革蘭氏陰性菌。丹麥細(xì)菌學(xué)家革蘭(Hans Christian Gram),他發(fā)明了革蘭氏染色。經(jīng)過(guò)染色細(xì)菌仍然保留初染結(jié)晶紫的藍(lán)紫色為革蘭氏陽(yáng)性菌,經(jīng)過(guò)染色細(xì)菌脫去了初染結(jié)晶紫的顏色,帶上了蕃紅或沙黃的紅色為革蘭氏陰性菌。
放線菌屬 //

圖10. Actinobacterium sp.(放線菌屬)
圖源網(wǎng)絡(luò),僅供參考學(xué)習(xí)用
鑒定結(jié)果:樣本3 為 Actinobacterium sp.(放線菌屬)
類別:G+菌
形狀:絲狀;菌落呈放射狀
大。寬度近于桿狀細(xì)菌,直徑0.5~1 μm
代表屬:鏈霉菌屬,多達(dá)1000多種,大家所熟知的鏈霉素就是其代謝產(chǎn)物
分布范圍:土壤、空氣和水中,尤其是含水量低、有機(jī)物豐富、呈中性或微堿性的土壤中數(shù)量最多。土壤特有的泥腥味,主要是放線菌的代謝產(chǎn)物所致
羅爾斯通菌屬 //

圖11. Ralstonia sp.(羅爾斯通菌屬)
圖源網(wǎng)絡(luò),僅供參考學(xué)習(xí)用
鑒定結(jié)果:樣本4 定序?yàn)?Ralstonia sp.(羅爾斯通菌屬)
類別:G-菌
形狀:桿狀;菌落呈圓形臍狀凸起,無(wú)色透明,表面光滑濕潤(rùn),邊緣不規(guī)則
大。1.2×2.5~3.5 μm
代表種:植物青枯菌,寄主范圍很廣泛,可以侵染茄科、豆科、蓼科、紫草科、鳳仙花科等44科200多種植物。除煙草外,番茄、花生、辣椒、茄子、芝麻、生姜、馬鈴薯以及棉、木麻黃、油橄欖、桑都可受感染,但不危害禾本科植物
分布范圍:土壤和水等環(huán)境源中
短波單胞菌屬 //
圖12. Brevundimonas vesicularis(泡囊假單胞菌)
圖源網(wǎng)絡(luò),僅供參考學(xué)習(xí)用
鑒定結(jié)果:樣本5 為 Brevundimonas sp.(短波單胞菌屬)
類別:G-菌
形狀:桿狀;菌落為圓形,凸起,表面濕潤(rùn)光滑,邊緣整齊
大。0.4~0.5x1-2 μm
代表種:泡囊短波單胞菌是一種較罕見(jiàn)的非發(fā)酵性病原性假單胞菌,在人體可引起肺炎、敗血癥、皮膚炎癥和壞死性蜂窩織炎等
分布范圍:通常存在于土壤、河流等自然界中
泳池芽殖單胞菌 //

圖13. Blastomonas(芽單胞菌屬)
圖源網(wǎng)絡(luò),僅供參考學(xué)習(xí)用
鑒定結(jié)果:樣本13 為 Blastomonas natatoria(泳池芽殖單胞菌)
類別:G-菌
形狀:卵圓形或桿狀,含有黃色或橙褐色色素。與芽單胞菌屬關(guān)系:泳池芽殖單胞菌是芽單胞菌屬的一種,通過(guò)出芽方式繁殖
分布范圍:通常存在于土壤、河流等自然界中
假單胞菌屬 //

圖14. Pseudomonas (假單胞菌屬)
圖源網(wǎng)絡(luò),僅供參考學(xué)習(xí)用
鑒定結(jié)果:樣本27 定序?yàn)?Pseudomonas sp.(假單胞菌屬
類別:G-菌
形狀:桿狀;菌落多呈藍(lán)綠色或熒光色,有生姜味
大。(0.5~1)×(1.5~4) μm
代表種:假單胞菌屬種類繁多,含有200余種。代表種綠膿假單胞菌,因能產(chǎn)生綠色水溶性色素,感染創(chuàng)口時(shí)可形成綠色膿液而得名。本菌是條件性致病菌,一般為繼發(fā)性感染,如大面積燒傷的創(chuàng)面感染、中耳炎、泌尿系統(tǒng)感染感染,甚至敗血癥
分布范圍:主要分布在水、土壤和空氣中,在臨床標(biāo)本如傷口創(chuàng)面分泌物、膿汁、血液等檢出率較高,是醫(yī)院內(nèi)感染常見(jiàn)的條件致病菌
鞘脂菌屬 //

圖15. Sphingobium(鞘脂菌屬)
圖源網(wǎng)絡(luò),僅供參考學(xué)習(xí)用
鑒定結(jié)果:樣本2 定序?yàn)?Sphingobium sp.(鞘脂菌屬)
類別:G-菌
形狀:桿狀; 菌落直徑1.0-2.0mm,黃色,圓形
大。 (0.5~1)×(1.5~4) μm
特點(diǎn):該細(xì)菌嚴(yán)格好氧,無(wú)芽孢,生長(zhǎng)溫度為10-40 ℃;最適生長(zhǎng)溫度為30-37 ℃。生長(zhǎng)的pH值范圍是5.5-9.0,最佳pH值在6.5到8.0之間
分布范圍:主要從土壤中分離
鞘氨醇單胞菌屬 //

圖16. Sphingomonas(鞘氨醇單胞菌)
圖源網(wǎng)絡(luò),僅供參考學(xué)習(xí)用
鑒定結(jié)果:樣本7,8,11,23 為 Sphingomonas sp.(鞘氨醇單胞菌)
類別:G-菌
形狀:桿狀;菌落為黃色
大。0.3-0.8x1.0-2.7 µm
特點(diǎn):該菌屬至今共有12個(gè)種,是一類豐富的新型微生物資源,可用于芳香化合物的生物降解。該屬菌株憑借自身的高代謝能力與多功能的生理特性,在環(huán)境保護(hù)及工業(yè)生產(chǎn)方面具有巨大的應(yīng)用潛力
分布范圍:鞘氨醇單胞菌在環(huán)境中無(wú)處不在,河水、根際、地表及深層的地下的沉積物、海洋,甚至極地土壤中都有它們的蹤跡
甲基芽孢桿菌屬 //
圖17. Methylobacillus sp(甲基芽孢桿菌屬)
圖源網(wǎng)絡(luò),僅供參考學(xué)習(xí)用
鑒定結(jié)果:樣本16 為Methylobacillus sp.(甲基芽孢桿菌屬)
類別:G-菌
形狀:桿狀,以單極毛運(yùn)動(dòng)或不運(yùn)動(dòng);菌落形態(tài)為乳白色,透明,凸起,邊緣規(guī)則,生長(zhǎng)緩慢
大。0.8-1.0×1.0-8.0 μm
特點(diǎn):專性甲基營(yíng)養(yǎng)菌,只能生長(zhǎng)于除了甲醇外的 C1化合物,在甲烷中也不生長(zhǎng)。對(duì)果糖的利用因菌株而異。嚴(yán)格好氧,呼吸代謝
分布范圍:主要分布在水、土壤中
微桿菌屬 //
圖18. Microbacterium sp.(微桿菌屬)
圖源網(wǎng)絡(luò),僅供參考學(xué)習(xí)用
鑒定結(jié)果:樣本21、22 定序?yàn)镸icrobacterium sp.(微桿菌屬)
類別:G+菌
形狀:桿狀 ;菌落淺黃色,圓形,表面光滑、濕潤(rùn)、稍凸,不透明
大。1-10 µm long and between 0.2-0.6 µm wide
特點(diǎn):微桿菌屬目前已知有40種;此類細(xì)菌特點(diǎn)不生孢,不抗酸。不運(yùn)動(dòng)或以1~3根鞭毛運(yùn)動(dòng)。好氧,弱厭氧;墚愷B(yǎng)菌,以呼吸代謝為主,也可能弱發(fā)酵。利用葡萄糖和一些其他糖產(chǎn)酸。營(yíng)養(yǎng)要求復(fù)雜。最適生長(zhǎng)溫度30℃
分布范圍:微桿菌屬的成員可以從廣泛的環(huán)境中分離出來(lái),包括土壤、昆蟲(chóng)、海洋環(huán)境、植物、乳制品等
赫氏草螺菌 //

圖19. Herbaspirillum spp.(草螺菌屬)
圖源網(wǎng)絡(luò),僅供參考學(xué)習(xí)用
鑒定結(jié)果:樣本24、25、26、29 定序?yàn)镠erbaspirillum huttiense(赫氏草螺菌)
類別:G-菌
形狀:螺旋型;菌落呈圓形,淡黃色不透明,表面褶皺,干燥,無(wú)暈環(huán),無(wú)凸起,直徑約1mm
大。長(zhǎng)度至數(shù)十微米;螺旋波長(zhǎng)為 5-15 µm,螺旋幅度約一乃至數(shù)微米
特點(diǎn):赫氏草螺菌,具有低溫固氮的能力,是堆肥技術(shù)應(yīng)用得以保氮固氮的優(yōu)秀功能菌株之一。近年來(lái),隨著草螺菌研究的不斷深入,發(fā)現(xiàn)草螺菌具有固氮或產(chǎn)生植物激素的功能并具有使宿主植物增產(chǎn)的潛能
分布范圍:在土壤和其他自然環(huán)境中分布廣泛,是土壤和植物微生態(tài)優(yōu)勢(shì)種群之一
// 小結(jié) //
在檢測(cè)的18個(gè)黑膠蟲(chóng)樣本中,大多數(shù)細(xì)菌呈桿狀,只有極個(gè)別的細(xì)菌呈絲狀或螺旋型,這和觀察到的大多數(shù)黑膠蟲(chóng)呈桿狀相符。通過(guò)測(cè)序鑒定,可推測(cè)黑膠蟲(chóng)的身真實(shí)身份極有可能是細(xì)菌。

好啦~
本期分析到這里也就結(jié)束啦~
如果您也想鑒定您的細(xì)胞是否有黑膠蟲(chóng)污染
快來(lái)參加逍鵬生物的
“黑膠蟲(chóng)通緝令”吧~
歡迎關(guān)注公眾號(hào)留言咨詢,給您最合適的解決方案~

了解詳細(xì)信息可戳原文,轉(zhuǎn)載請(qǐng)標(biāo)明出處。
BI 中國(guó)市場(chǎng)部:上海逍鵬生物科技有限公司